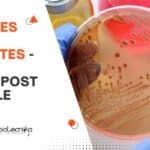
Cipla Vacancies For BSc

Home Search
microbiology - search results
If you're not happy with the results, please do another search
Biotecnika Times Newsletter 13.06.2023 Indian Pharmacopoeia Commission Jobs, FSSAI Internship
Biotecnika Times Newsletter 13.06.2023 Indian Pharmacopoeia Commission Jobs, FSSAI Internship
Indian Pharmacopoeia Commission (IPC) MSc, PhD Biotech, Biochem & Microbiology Jobs With Up to Rs....
FSSAI Internship Scheme For July 2023 With Rs. 10,000 Stipend, Apply Online
FSSAI Internship 2023 July Scheme, Apply Online
FSSAI Internship 2023 July Scheme, Apply Online. Food Safety and Standards Authority of India Internship 2023. Internship Scheme...
Biotecnika Times Newsletter 12.06.2023 IICT Multiple Project Jobs, Trainee Opportunity, CRISPR Workshop, Summer Internships
Biotecnika Times Newsletter 12.06.2023 IICT Multiple Project Jobs, Trainee Opportunity, CRISPR Workshop, Summer Internships
CSIR-IICT MSc, MTech, BTech, BSc & PhD Life, Biological Sciences, Genetics,...
Pepsico Food Safety Scientist Job Opening, Apply Online
Pepsico Food Safety Scientist Job Opening, Apply Online
Pepsico Food Safety Scientist Job Opening, Apply Online. Interested and eligible candidates can check the details and...
Looking For Trainee Opportunity? Colgate-Palmolive Is Hiring – Apply Online If You Fit...
Colgate-Palmolive Research Trainee Microbiology, Apply Online
Colgate-Palmolive Research Trainee Microbiology, Apply Online. Looking For Trainee Opportunity? Colgate-Palmolive Is Looking - Apply Online If You Fit...
Biotecnika Times Newsletter 09.06.2023 Summer Internship CUH, Non-NET Job Opportunities, Pfizer & Sanofi Hiring
Biotecnika Times Newsletter 09.06.2023 Summer Internship CUH, Non-NET Job Opportunities, Pfizer & Sanofi Hiring
Summer Internship (SSR) Scheme of DST-SERB at CUH, Applications Invited...
NIAB Project Associate Job For MSc, MTech Life Sciences – Apply Online
NIAB Job 2023 Biotech, Biochem, Life Sciences & Microbiology
NIAB Job 2023 Biotech, Biochem, Life Sciences & Microbiology. National Institute of Animal Biotechnology vacancies. MSc,...
MSc Biotech, Biochem, Genetics, Mol Bio, Life Sciences Associate Job at Clarivate, Apply Online
Clarivate MSc Associate Content Editor Opportunity, Apply Online
Clarivate MSc Associate Content Editor Opportunity, Apply Online. MSc Biotechnology, Biochem, Genetics, Microbiology and Mol Bio Job....
Biotecnika Times Newsletter 08.06.2023 Internship at Siemens Healthineers, Pepsi Hiring, CSIR NET June 2023...
Biotecnika Times Newsletter 08.06.2023 Internship at Siemens Healthineers, Pepsi Hiring, CSIR NET June 2023 Paper Analysis
Siemens Healthineers Intern - Bioinformatics Recruitment, Apply Online
Siemens Healthineers...
Clarivate MSc Biotech Associate Content Editor Opportunity, Apply Online
Clarivate MSc Biotech Associate Content Editor Opportunity, Apply Online
Clarivate MSc Biotech Associate Content Editor Opportunity, Apply Online. MSc Biotechnology Job. Apply online for the...
Anabio, Bangalore Hiring For Chief Business Officer Role – Salary: Rs 20-25 Lakhs –...
Anabio Bangalore Hiring For Chief Business Officer Role, Applications Invited
Position: Chief Business Officer
This is a mission-critical leadership role, and the candidate will be responsible...
Biotecnika Times Newsletter 07.06.2023 Freshers Jobs at SJRI & Charles River, Cipla Hiring
Biotecnika Times Newsletter 07.06.2023 Freshers Jobs at SJRI & Charles River, Cipla Hiring
Freshers MSc Biotech, Biochem Research Assistant Job at SJRI, Apply Online
Freshers MSc...
Cipla Vacancies For BSc Candidates – Jr. Team Member Post Available
Cipla Vacancies For BSc Candidates - Jr. Team Member Post Available
Cipla Vacancies For BSc Candidates - Jr. Team Member Post Available. BSc Microbiology Jobs....
Vasantdada Sugar Institute Pune MSc, BTech & MTech Biotech, Biochem, Microbio Research Jobs
Vasantdada Sugar Institute MSc, BTech & MTech Biotech, Biochem, Microbio Research Jobs
Vasantdada Sugar Institute MSc, BTech & MTech Biotech, Biochem, Microbio Research Jobs. Vasantdada...
SRM University-AP Admission Open 2023 For MSc Molecular Biology & Biotechnology
SRM University-AP Admission Open 2023 For MSc Molecular Biology & Biotechnology
M.Sc Molecular Biology and Biotechnology
SRM University – AP, Andhra Pradesh
Admission open - 2023
About the...